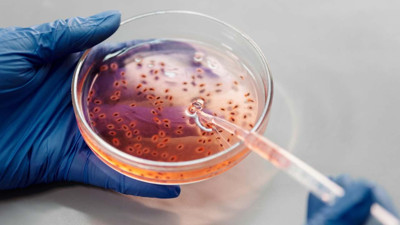
ABD'de daha önce insanlarda görülmeyen virüs can aldı!

- Yazarlar
- Ekonomi
- Finans
- Gündem
- Sektör Haberleri
- Dünya
- Foto Galeri
- Video Galeri
- e-Dünya
- İş Dünyası
- İklim Ekonomisi
- Tekstil
- Teknoloji
-
KOBİ
- Dünya 45 Yaşında
- Sigortacılık
- Otomotiv
- Makine
- Kültür-Sanat
- Lojistik
- Tarım
- Fintech
- Yaşam Keyfi
-
Dünya +

-
Dünya #

- Sürdürülebilir Dünya
- Yaşam
- Sağlık
- Künye
© 2020 Dünya. Tüm hakları saklıdır. İçeriklerin izinsiz kopyalanması yasaktır.
Bu site deneyimlerinizi kişiselleştirmek amacıyla KVKK ve GDPR uyarınca çerez(cookie) kullanmaktadır. Bu konu hakkında detaylı bilgi almak için çerez politikası ve aydınlatma metni sayfalarını gözden geçirebilirsiniz. Sitemizi kullanarak, çerezleri kullanmamızı kabul edersiniz.